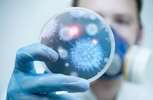

Здоров'я
Станом на ранок 27 жовтня 2021 року в Житомирській області лабораторно підтверджено 111292 випадки коронавірусної хвороби, з них 711 виявили упродовж минулої доби, 26 жовтня. Загалом від ускладнень СOVID-19 в області померли 2339 людей, упродовж минулої доби зафіксували 23 летальні випадки.
Станом на ранок 26 жовтня 2021 року в Житомирській області лабораторно підтверджено 110581 випадок коронавірусної хвороби, з них 286 виявили упродовж минулої доби, 25 жовтня. Загалом від ускладнень СOVID-19 в області померли 2316 людей, упродовж минулої доби зафіксували 30 летальних випадків.
Станом на ранок 25 жовтня 2021 року в Житомирській області лабораторно підтверджено 110295 випадків коронавірусної хвороби, з них 1042 виявили упродовж минулої доби, 24 жовтня. Загалом від ускладнень СOVID-19 в області померли 2286 людей, упродовж минулої доби зафіксували 13 летальних випадків.
Станом на ранок 24 жовтня 2021 року в Житомирській області лабораторно підтверджено 109254 випадки коронавірусної хвороби, з них 951 виявили упродовж минулої доби, 23 жовтня. Загалом від ускладнень СOVID-19 в області померли 2273 людини, упродовж минулої доби зафіксували 24 летальні випадки.
Станом на ранок 23 жовтня 2021 року в Житомирській області лабораторно підтверджено 108303 випадки коронавірусної хвороби, з них 1145 виявили упродовж минулої доби, 22 жовтня. Загалом від ускладнень СOVID-19 в області померли 2249 людей, упродовж минулої доби зафіксували 17 летальних випадків.
Станом на ранок 22 жовтня 2021 року в Житомирській області лабораторно підтверджено 107158 випадків коронавірусної хвороби, з них 1144 виявили упродовж минулої доби, 21 жовтня. Загалом від ускладнень СOVID-19 в області померли 2232 людини, упродовж минулої доби зафіксували 25 летальних випадків.